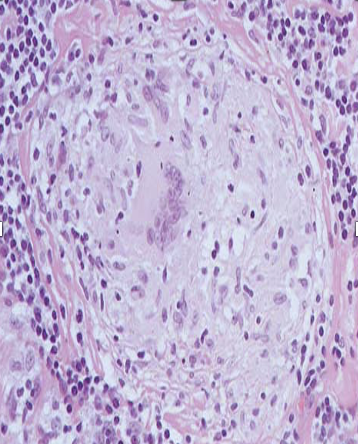

inflammation of bone & bone marrow caused by pyogenic bacterial infection is know as
pyogenic osteomyelitis
first site of infection in osteomyelitis
metaphysis of long bone
any bone
Vertebral column
this is a presentation of

chronic�������� ��������������������� ��������������������� ��������������pyogenic osteomyelitis
Identify what is 3 pointed by arrow

main cloaca
Identify what is 2 pointed by arrow

involcrum
Identify what is 1 pointed by arrow

sequestrum
Identify what is 6 pointed by arrow
seen in case of chronic osteomyelitis

mixed inflammatory exudate
Identify what is 5 pointed by arrow
seen in case of chronic osteomyelitis

bone trabeculae
when pus penetrates Haversian system of the metaphysis , it will lead to
subperiosteal abscess
Fragments of necrotic bone
embedded in pus is known as
Sequestrum
Perisoteal reactive new (woven) bone
formation around necrotic sequestrum
is known as
Involucrum
a hole / tract formed in the bone
formation of draining sinus is known as
cloaca
Route of Infection of Pyogenic Spondyelitis
Arterial haematogenous
common locations of Pyogenic Spondyelitis
thoracic , lumbar
spontaneous bone fusion is known as
Ankylosis
Mention at least 4 COMPLICATIONS OF OSTEOMYELITIS
1- septic bacterial arthritis
2- chronic osteomyelitis
3- pathological fractures
4- septicaemia
5- SCC
6- amyloidosis
Initial focus of TB osteomyelitis in adults
metaphysis
Initial focus of TB osteomyelitis in children
epiphysis
pott’s disease location
lower thoracic & lumber vertebrae
mention at least 3 Complications of Pott’s Disease
1- cold abscess
2- rupture into soft tissue
3- angulations of spine
main vertebral deformity seen in pott’s disease
Kyphosis
what type of multinucleated giant cells are seen here
Langhan’s type of multinucleated giant cells
Identify what is 3 pointed by the arrows
Diagnose the case

-Multiple granulomas
seen in TB Spondylitis
fused bone or other hard tissue in seen in
septic arthritis


